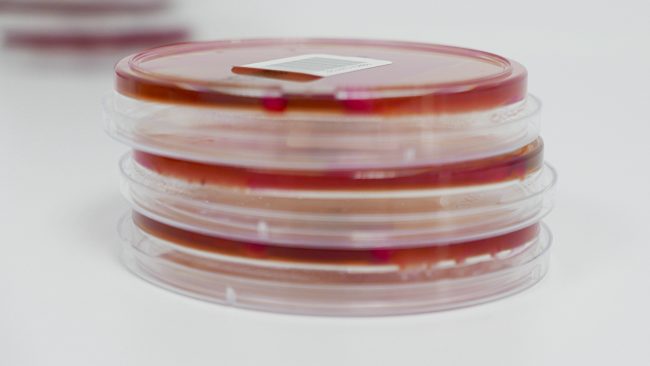

Streptococcus suis
La Streptococcus suis es una de las principales bacterias patógenas que afectan a los cerdos, causando diversas enfermedades que pueden tener un impacto significativo en la producción porcina. Esta bacteria es particularmente compleja debido a la gran variedad de serotipos que presenta. Hasta la fecha, se han identificado más de 35 serotipos diferentes de Streptococcus…